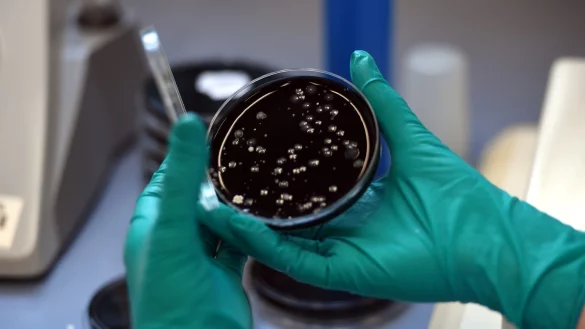
Legionellen - &copy; Foto: picture alliance / dpa

Viele Menschen haben sich schon darauf gefreut: Nach der Corona-Zwangspause öffnen die Hotels und Sportstätten wieder. Bei der Nutzung der Sanitäranlagen ist nun aber besondere Vorsicht geboten.
Corona-Pause
RKI warnt vor Legionellen-Risiko in Wasseranlagen